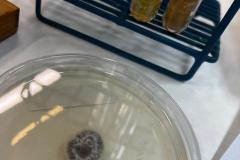
3

Galerias de Imagens
-

Visitas Técnicas
11/03/2026
-
Esporotricose
26/02/2026
-

Reunião CIPA
26/09/2025
-

rotulagem
12/09/2025
-

simulação arbo
12/09/2025
-

CGLAB/TB/HAN
29/05/2025
-

Visita FiocruzCE
13/12/2024
-

130 anos
10/12/2024
-

Sorologia OROV IEC
25/11/2024
-

XI EAIL
13/11/2024
-

Envento DDA Foz 2024
01/11/2024
-

Menigites foz
22/10/2024


